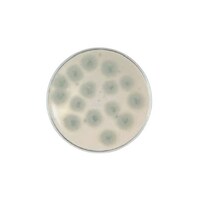
日本ベクトン・ディッキンソン BD BBL(TM)ポテトデキストロースCP 寒天培地 1個(1本×20枚入)

日清食品チルド 【冷蔵】日清食品チルド 鍋焼 日清ラ王 チャンポン 1人前 133g×6個
【鍋焼 日清ラ王 チャンポン】常温保存可能な鍋焼チャンポン。麺はもっちり食感の生めん。魚介と野菜の旨みを凝縮した豚骨ベースのまろやかなスープ。1食分の野菜(乾燥具材)入り!
【鍋焼 日清ラ王 チャンポン】常温保存可能な鍋焼チャンポン。麺はもっちり食感の生めん。魚介と野菜の旨みを凝縮した豚骨ベースのまろやかなスープ。1食分の野菜(乾燥具材)入り!+もっと見る
日清食品チルド 【冷蔵】日清食品チルド 鍋焼 日清ラ王 豚骨醤油 1人前 129g×6個
【鍋焼 日清のラ王 豚骨醤油 もっちり生めん】常温保存可能な鍋焼ラーメン。麺はもっちり食感の生めん。鶏ガラと豚骨のコクと旨みがきいた濃厚豚骨醤油スープ。
【鍋焼 日清のラ王 豚骨醤油 もっちり生めん】常温保存可能な鍋焼ラーメン。麺はもっちり食感の生めん。鶏ガラと豚骨のコクと旨みがきいた濃厚豚骨醤油スープ。+もっと見る
クリニコ エンジョイゼリープラス(栄養補助食品) いろいろセット 1箱(30個入り) 7909011
手軽においしく栄養補給ができる、常温保存可能なゼラチン配合ゼリーです。エネルギー360kcal、たんぱく質14.4gが補給できます(1パック220g当たり)。12種類のビタミンを配合。
手軽においしく栄養補給ができる、常温保存可能なゼラチン配合ゼリーです。エネルギー360kcal、たんぱく質14.4gが補給できます(1パック220g当たり)。12種類のビタミンを配合。+もっと見る
国分 まごころを食卓に膳 ぶり大根 130g×30 4901592927187 レトルト食品(その他) 1セット(130g入×30)
まごころを食卓に膳は、暮らしに寄り添い、食卓をあたたかく彩る、常温保存のお惣菜です。国産のぶりと大根を、味がしみるまで炊き上げました。レンジ対応パウチ商品です。
まごころを食卓に膳は、暮らしに寄り添い、食卓をあたたかく彩る、常温保存のお惣菜です。国産のぶりと大根を、味がしみるまで炊き上げました。レンジ対応パウチ商品です。+もっと見る
国分 まごころを食卓に膳 土佐煮80g×30 4901592927101 レトルト食品(その他) 1セット(80g入×30)
まごころを食卓に膳は、暮らしに寄り添い、食卓をあたたかく彩る、常温保存のお惣菜です。まごころをこめてお届けします。かつお節と昆布のだしで、穂先たけのことふきを炊きあげました。
まごころを食卓に膳は、暮らしに寄り添い、食卓をあたたかく彩る、常温保存のお惣菜です。まごころをこめてお届けします。かつお節と昆布のだしで、穂先たけのことふきを炊きあげました。+もっと見る
国分 まごころを食卓に膳 きんぴらごぼう 70g×30 4901592927132 レトルト食品(その他) 1セット(70g入×30)
まごころを食卓に膳は、暮らしに寄り添い、食卓をあたたかく彩る、常温保存のお惣菜です。まごころをこめてお届けします。国産のごぼうとれんこんを使用し、シャキシャキした食感に仕上げました。
まごころを食卓に膳は、暮らしに寄り添い、食卓をあたたかく彩る、常温保存のお惣菜です。まごころをこめてお届けします。国産のごぼうとれんこんを使用し、シャキシャキした食感に仕上げました。+もっと見る
熊本県酪農業協同組合連合会 らくのうマザーズ 大阿蘇牛乳 4908839181111 冷凍・冷蔵食品(乳製品) 24個(200ml×24個)
常温保存可能な成分無調整牛乳です。飲みきりサイズの200mlパックです。デザインには熊本県営業部長兼しあわせ部長のくまモンを採用しています。常温保存できるので日常的に利用しながら、日常備蓄、災害備蓄、
常温保存可能な成分無調整牛乳です。飲みきりサイズの200mlパックです。デザインには熊本県営業部長兼しあわせ部長のくまモンを採用しています。常温保存できるので日常的に利用しながら、日常備蓄、災害備蓄、+もっと見る
国分 まごころを食卓に膳 牛すじ煮込み 100g×30 4901592927156 レトルト食品(その他) 1セット(100g入×30)
まごころを食卓に膳は、暮らしに寄り添い、食卓をあたたかく彩る、常温保存のお惣菜です。国産の牛すじを、野菜とともに濃厚なブラウンソースでじっくり煮込みました。レンジ対応パウチ商品です。
まごころを食卓に膳は、暮らしに寄り添い、食卓をあたたかく彩る、常温保存のお惣菜です。国産の牛すじを、野菜とともに濃厚なブラウンソースでじっくり煮込みました。レンジ対応パウチ商品です。+もっと見る
国分 まごころを食卓に膳 切干大根煮 85g ×30 4901592927149 レトルト食品(その他) 1セット(85g入×30)
まごころを食卓に膳は、暮らしに寄り添い、食卓をあたたかく彩る、常温保存のお惣菜です。まごころをこめてお届けします。国産大根の切干大根を、かつおだしでやさしい味わいに仕上げました。
まごころを食卓に膳は、暮らしに寄り添い、食卓をあたたかく彩る、常温保存のお惣菜です。まごころをこめてお届けします。国産大根の切干大根を、かつおだしでやさしい味わいに仕上げました。+もっと見る
国分 まごころを食卓に膳 十目ひじき煮 70g ×30 4901592927118 レトルト食品(その他) 1セット(70g入×30)
まごころを食卓に膳は、暮らしに寄り添い、食卓をあたたかく彩る、常温保存のお惣菜です。まごころをこめてお届けします。10種類の具材を、かつお節と昆布のだしで仕上げたひじき煮です。
まごころを食卓に膳は、暮らしに寄り添い、食卓をあたたかく彩る、常温保存のお惣菜です。まごころをこめてお届けします。10種類の具材を、かつお節と昆布のだしで仕上げたひじき煮です。+もっと見る
国分 まごころを食卓に膳 豚の角煮 140g×30 4901592927224 レトルト食品(その他) 1セット(140g入×30)
まごころを食卓に膳は、暮らしに寄り添い、食卓をあたたかく彩る、常温保存のお惣菜です。柔らかく煮込んだ豚の角煮とたけのこを、生姜香る味わいに仕上げました。レンジ対応パウチ商品です。
まごころを食卓に膳は、暮らしに寄り添い、食卓をあたたかく彩る、常温保存のお惣菜です。柔らかく煮込んだ豚の角煮とたけのこを、生姜香る味わいに仕上げました。レンジ対応パウチ商品です。+もっと見る
国分 まごころを食卓に膳 いわしの梅煮 2尾×30 4901592927231 レトルト食品(その他) 1セット(2尾入×30)
まごころを食卓に膳は、暮らしに寄り添い、食卓をあたたかく彩る、常温保存のお惣菜です。まごころをこめてお届けします。国産のいわしを、梅肉でさっぱりと仕上げました。レンジ対応パウチ商品です。
まごころを食卓に膳は、暮らしに寄り添い、食卓をあたたかく彩る、常温保存のお惣菜です。まごころをこめてお届けします。国産のいわしを、梅肉でさっぱりと仕上げました。レンジ対応パウチ商品です。+もっと見る
国分 まごころを食卓に 膳 さばの塩焼き 2切x30 4901592927170 レトルト食品(その他) 1セット(2個x30)
まごころを食卓に膳は、暮らしに寄り添い、食卓をあたたかく彩る、常温保存のお惣菜です。まごころをこめてお届けします。焼目を付けた鯖を2切れ入れました。程よい塩味が食欲をそそります。
まごころを食卓に膳は、暮らしに寄り添い、食卓をあたたかく彩る、常温保存のお惣菜です。まごころをこめてお届けします。焼目を付けた鯖を2切れ入れました。程よい塩味が食欲をそそります。+もっと見る
国分 まごころを食卓に膳 野菜の塩こうじ煮120g×30 4901592927125 レトルト食品(その他) 1セット(120g入×30)
まごころを食卓に膳は、暮らしに寄り添い、食卓をあたたかく彩る、常温保存のお惣菜です。6種類の具材を、食感を大切に、塩こうじで仕上げました。レンジ対応パウチ商品です。
まごころを食卓に膳は、暮らしに寄り添い、食卓をあたたかく彩る、常温保存のお惣菜です。6種類の具材を、食感を大切に、塩こうじで仕上げました。レンジ対応パウチ商品です。+もっと見る
国分 まごころを食卓に膳 鶏手羽の黒酢煮 165g×30 4901592927194 レトルト食品(その他) 1セット(165g入×30)
まごころを食卓に膳は、暮らしに寄り添い、食卓をあたたかく彩る、常温保存のお惣菜です。国産の鶏手羽を、鹿児島の壺造り黒酢仕立てのたれで柔らかく仕上げました。レンジ対応パウチ商品です。
まごころを食卓に膳は、暮らしに寄り添い、食卓をあたたかく彩る、常温保存のお惣菜です。国産の鶏手羽を、鹿児島の壺造り黒酢仕立てのたれで柔らかく仕上げました。レンジ対応パウチ商品です。+もっと見る
日本ベクトン・ディッキンソン BD BBL(TM)ポテトデキストロースCP 寒天培地 1個(1本×20枚入)
食品検査に用いらるクロラムフェニコール入りの酵母及びカビ用です。常温保存で6か月の有効期限です。
食品検査に用いらるクロラムフェニコール入りの酵母及びカビ用です。常温保存で6か月の有効期限です。+もっと見る
16件中1~16件を表示中
- 1